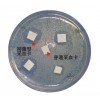

|
公司基本資料信息
|
||||||||||||||||||||
?
?
產品詳細說明
抑菌型血樣采集卡(進口基材)
抑菌型DNA存儲卡(DNA血樣采集卡)是一種以植物纖維為載體用于存儲DNA的新型介質,專為室溫下對各種生物體液(如血液、精液、唾液)、細胞培養液、微生物、植物組織和病毒等樣品進行收集、運輸和存儲而設計。(進口基材)
價格:700.00元/盒
包裝數量:100份
?
更多..本企業其它產品
以上信息由企業自行提供,信息內容的真實性、準確性和合法性由信息上傳的相關企業負責,應安網對此不承擔任何法律及保證責任。
網站首頁 | 聯系方式 | 使用協議 | 版權隱私 | 網站地圖 | 網站留言 | 廣告服務 | 京公網安備11010702001235 | 京ICP備13026831號-1
Copyright Reserved 2009-2018 版權所屬:北京啟翰科技有限公司? 應安網 客服中心010-88795992 應安網提供技術支持

[第8年] 指數:7
[第8年] 指數:7 通過認證
通過認證 













